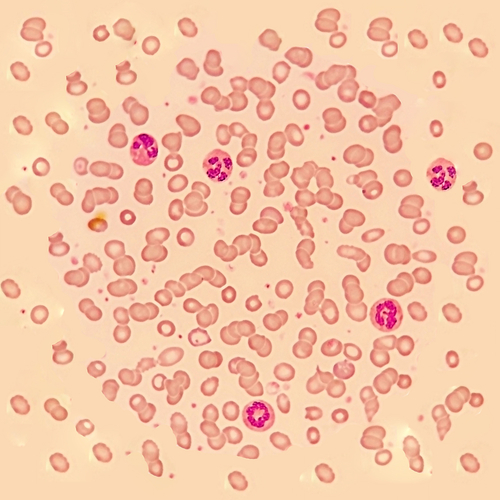

A first stem cell transplant after CAR T-cell therapy reduces relapses in ALL
American Society of Hematology Newsroom Dec 04, 2018
In a new study, patients with ALL who received a first stem cell transplant after CD19 CAR T-cell therapy were less likely to experience a relapse of their cancer when compared to similar patients who didn’t undergo transplantation.
This is one of the first studies to evaluate the potential role stem cell transplantation plays in long-term outcomes after CD19 CAR T-cell therapy for pediatric patients, said lead study author Corinne Summers, MD, of the Seattle Children's Hospital and Fred Hutchinson Cancer Research Center.
“We see a trend toward improved leukemia-free survival in pediatric patients who receive their first stem cell transplant following CAR T-cell therapy,” Dr. Summers said.
In addition, either a first or a repeat stem cell transplant after CAR T-cell therapy reduced the risk of relapse in a subset of patients who were at elevated risk of having their cancer come back.
Many patients go into remission following CAR T-cell therapy, Dr. Summers said, but there are also relapses beyond one year following treatment. The goal of the study was to evaluate whether stem cell transplantation could make remissions last.
In this phase I/II trial, researchers analyzed 64 ALL patients who had received an infusion of their own T cells that had been reprogrammed to recognize and target the CD19 protein found on the surface of most leukemia cells. Patients had previously relapsed or had not responded to other treatment. Follow-up monitoring occurred for at least one year.
Fourteen patients relapsed, died, or did not respond to the CAR T-cell therapy. Of the 50 patients who achieved a sustained remission after CAR T-cell therapy, 34 had a history of previous stem cell transplant.
There were several cohorts observed:
- Of 24 patients who had a previous stem cell transplant but did not undergo a second one following CAR T-cell therapy, seven remain in remission.
- Among the 10 patients who had their second stem cell transplant following CAR T-cell therapy, five remain alive and in remission after at least 24 months of follow-up.
- Among the 16 patients who had not had a previous stem cell transplant, 13 had one after receiving CAR T-cell therapy. One of these patients relapsed following the stem cell transplant.
- Of the three patients who did not have a stem cell transplant after CAR T-cell therapy, two relapsed and the third remains in remission after 28 months of follow-up.
One of the expected effects of CAR T-cell therapy is a decrease in B cells following the procedure. This effect, known as B-cell aplasia, occurs because CAR T-cell therapy kills both normal and cancerous B cells. Continued B-cell aplasia is regarded as an indicator that the CAR T cells are still actively preventing the patient’s cancer from coming back. By contrast, short B-cell aplasia — that is, when B-cell counts begin to increase after CAR T-cell therapy — indicates that the CAR T-cells may no longer be working.
In the current analysis of patients who had been followed for at least a year, those with short B-cell aplasia who had a stem cell transplant after CAR T-cell therapy were less likely to relapse, regardless of whether the transplant was their first or their second. In this group of eight patients, one died of transplant-related complications and two relapsed. By contrast, all six patients with short B-cell aplasia who did not undergo stem cell transplant after CAR T-cell therapy relapsed.
Among patients who had a stem cell transplant after CAR T-cell therapy, all relapses thus far have occurred within two years, said Dr. Summers. However, among patients who did not have a stem cell transplant following CAR T-cell therapy, relapses continue to occur two or more years after treatment.
“For pediatric patients who achieve remission after CAR T-cell therapy, undergoing a first stem cell transplant following CD19 CAR T-cell therapy appears to be beneficial,” said Dr. Summers. “For patients who achieve remission, but have a higher risk of relapse because of short B-cell aplasia, a stem cell transplant after CAR T-cell therapy appears to be beneficial whether or not they have had one previously.”
For patients with a previous stem cell transplant, the benefit of a second one after CAR T-cell therapy is unclear; it may be that among this group of patients, only those with short B-cell aplasia benefit from a second transplant, according to the authors.
Longer follow-up is needed to understand the reasons for long-term relapse after CD19 CAR T-cell therapy and whether patients with a prior stem cell transplant can benefit from receiving a second one following CAR T-cell therapy. Phase II of the trial, now underway, is testing the anti-CD19 CAR T-cell therapy in a larger group of patients with acute leukemia or lymphoma that has relapsed or been unresponsive to other therapy.
This study was supported by Stand up to Cancer, St. Baldrick’s Foundation, Alex’s Lemonade Stand, and Juno Therapeutics.
This article is a press release of a study presented at the 60th American Society of Hematology (ASH) Annual Meeting and Exposition, 2018. Read the original here.
-
Exclusive Write-ups & Webinars by KOLs
-
Daily Quiz by specialty
-
Paid Market Research Surveys
-
Case discussions, News & Journals' summaries